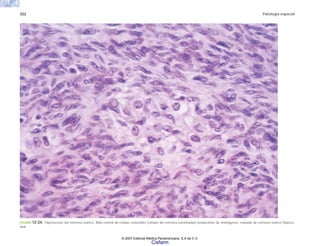
322 Patología especial
FIGURA 12-24. Hipertecosis del estroma ovárico. Nido central de células esteroides (células del estroma luteinizadas) productoras de andrógenos, rodeado de estroma ovárico hiperce-
lular.
© 2007 Editorial Médica Panamericana, S.A de C.V.
Cisfarm

El documento describe la evolución histórica de la patología en 5 periodos. El primero fue mágico-religioso, donde la enfermedad se veía como un castigo divino. Luego prevalecieron las teorías de los humores de Galeno durante 2000 años. El tercer periodo comenzó con Benivieni en el siglo 15, quien realizó las primeras autopsias para correlacionar hallazgos anatómicos con síntomas. El cuarto periodo incluyó a Fernel y Bonettus, quienes clasificaron enfermed